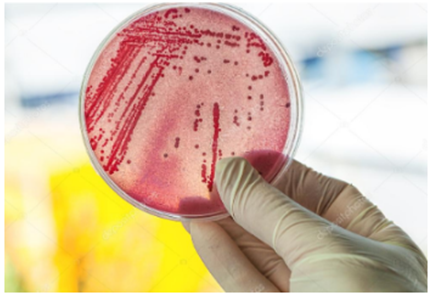

解決方案與產(chǎn)品應(yīng)用
COZIR-W在培養(yǎng)箱中的應(yīng)用
更新時間:2025-01-13 17:17:57
應(yīng)用介紹
一、什么是培養(yǎng)箱?
培養(yǎng)箱,是指溫度可控的、主要用于培養(yǎng)微生物、植物和動物細胞的箱體裝置,有的具有制冷和加熱的雙向調(diào)溫系統(tǒng),是生物、農(nóng)業(yè)、醫(yī)藥、環(huán)保等科研部門的基本實驗設(shè)備,廣泛應(yīng)用于恒溫培養(yǎng)、恒溫反應(yīng)等試驗。
培養(yǎng)箱的特點主要有:箱體采用聚氨酯等泡沫塑料作為隔熱材料,對外源冷、熱都有較好的隔絕能力;內(nèi)腔多采用不銹鋼制作,有較強的抗腐蝕能力;具有加熱、制冷以及自動溫控裝置.能靈敏地調(diào)節(jié)箱內(nèi)溫度。

二、培養(yǎng)箱需要監(jiān)測什么?
現(xiàn)在很多實驗室中用的都有培養(yǎng)箱,培養(yǎng)箱用于模擬生物體中細胞/組織樣生長環(huán)境的形成,例如穩(wěn)定的溫度、穩(wěn)定的二氧化碳水平、恒定的pH值為、以及相對較高的相對濕度等。
在使用培養(yǎng)箱過程要嚴格監(jiān)控培養(yǎng)箱內(nèi)氧氣以及二氧化碳的含量情況,因此,在二氧化碳培養(yǎng)箱的內(nèi)室中,通常提供大量的傳感器檢測元件。例如,溫度傳感器、二氧化碳傳感器、氧氣傳感器等。傳感器組合和微處理器放置在氣流路徑中,提供及時監(jiān)測氣流路徑中的溫度、 CO2以及氧氣濃度,以便最準(zhǔn)確地控制孵化器環(huán)境元素。
三、為什么要監(jiān)測二氧化碳?
一般來說,細胞培養(yǎng)基的酸堿度在7.0至7.4之間,由于碳酸鹽pH緩沖體系是一種生理pH緩沖體系,大多數(shù)培養(yǎng)液都是用它來維持穩(wěn)定的pH值,用粉末配制培養(yǎng)液時,往往需要加入一定量的碳酸鹽。對于大多數(shù)以碳酸鹽作為pH緩沖體系的培養(yǎng)液,為了保持pH穩(wěn)定,培養(yǎng)箱中的二氧化碳需要維持在2-10%之間,以維持培養(yǎng)液中溶解的二氧化碳濃度。
在這里,深圳市新世聯(lián)科技有限公司給大家推薦一款檢測CO2的傳感器COZIR-W,這款傳感器是英國GSS專門為檢測CO2研發(fā)的紅外光譜傳感器。
一、COZIR-W的概述
COZIR 是具有超低功耗(3.5mW)和高性能的CO2傳感器,是應(yīng)用于電池供電產(chǎn)品和便攜式設(shè)備的理想選擇;基于IR LED技術(shù)和創(chuàng)新的光路設(shè)計,使COZIR成為最低功耗的NDIR傳感器;并可選配溫度和濕度輸出。COZIR是GSS公司第三代產(chǎn)品,是IR LEDCO2傳感技術(shù)的領(lǐng)導(dǎo)者。量程分別是 0-5%,0-20%,0-60%和0-100%,這使得 COZIR-W 適合應(yīng)用于像潛水,工業(yè)安全和汽車制造行業(yè)。

二、COZIR-W的參數(shù)

三、COZIR-W的輸出
除了最基本的CO2濃度數(shù)字輸出外,該傳感器還可定制包含溫濕度輸出的數(shù)據(jù),以及模擬電壓輸出0.5-4V。

詳情請咨詢深圳市新世聯(lián)科技有限公司。